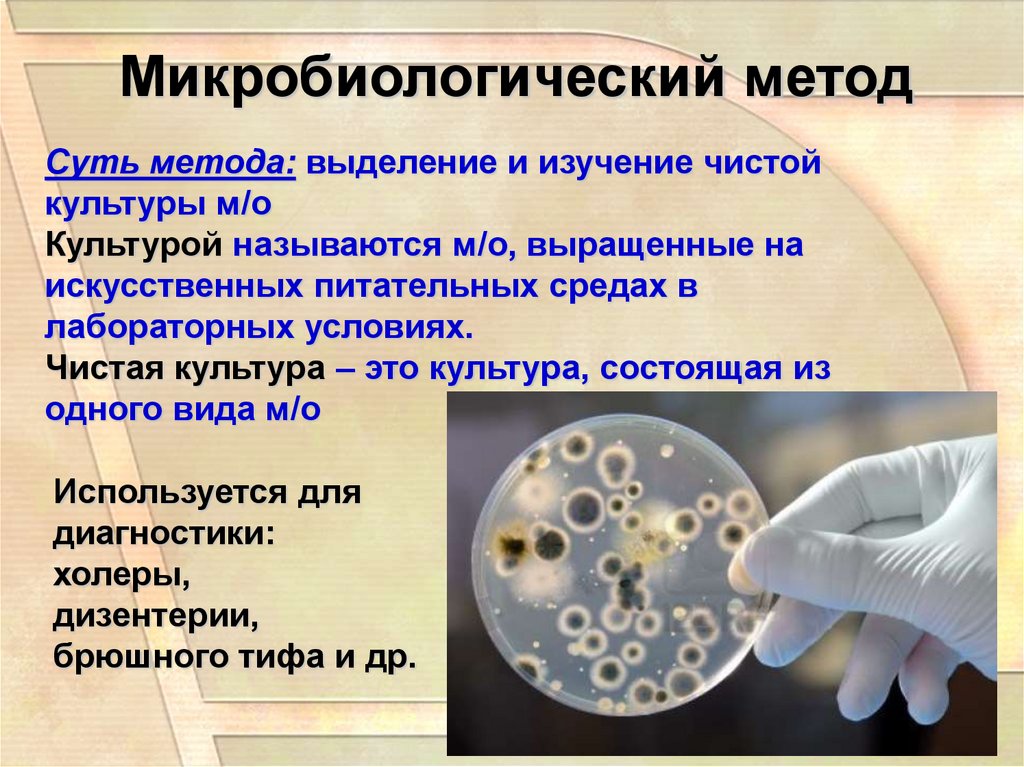

Похожие презентации:
Микробиологическая лаборатория. Методы микробиологических исследований
1.
Микробиологическаялаборатория
Методы микробиологических
исследований
2.
Микробиологические(бактериологические) лаборатории
организуются
при больницах, поликлиниках и СЭС.
Задача м/б лаборатории – диагностика
инфекционных болезней
3.
Материалом для исследований являются:1. Выделения человека (моча,
испражнения, мокрота, мазки,
гнойное отделяемое ран и др.)
2. Кровь, СМЖ, желчь, желудочный
сок, биопсийный материал,
трупный материал и др.
4.
Помещения м/б лаборатории1. Лабораторная комната
2. Бокс с предбоксником
3. Моечная
4. Помещение для приготовления питательных
сред
5. Стерилизационная
6. Регистратура
7. Виварий
5.
Лабораторная комнатаПредназначена для проведения м/б исследований
6.
Оборудование лабораторнойкомнаты:
Микроскопы:
Световой – предназначен для изучения
окрашенных мазков в микроскопе.
7. Микроскопы
• ЭлектронныйВирус гриппа
Электронный - предназначен для изучения вирусов.
8. Микроскопы
Темнопольный – предназначен для обнаружениявнутриклеточных паразитов
9. Микроскопы
Фазово – контрастный – предназначен для изучениянеокрашенных микроорганизмов.
10. Микроскопы
Люминисцентный – изучает светящиеся м/о послеспециальной обработки.
11.
ТермостатПредназначен для культивирования м/о в лабораторных
условиях на искусственных питательных средах.
T = + 37 градусов.
12.
ХолодильникВ холодильнике хранят некоторые питательные
среды, диагностический материал.
13.
ЦентрифугаПозволяет отделить плотные частицы от жидкости.
14.
Бокс с предбоксникомПредназначен для проведения работ,
требующих особой стерильности (посевов)
15.
МоечнаяПредназначена для дезинфекции и мытья
лабораторной посуды
16.
Помещение для приготовленияпитательных сред
17.
СтерилизационнаяПредназначена для стерилизации:
1. Питательных сред
2. Лабораторной посуды
3. Обеззараживания отработанного материала
18.
РегистратураВ регистратуре принимают, регистрируют
материал, поступающий для м/б
исследований, а также выдают заключение
м/б исследований
19.
ВиварийЭто помещение для содержания подопытных
животных
20.
Методы микробиологическихисследований
1. Микроскопический
2. Микробиологический
3. Серологический
4. Биологический
5. Аллергический
6. Молекулярно-генетический
21.
Микроскопический методСуть метода: изучение окрашенных мазков в
микроскопе. Он позволяет определить форму,
размеры, подвижность возбудителя, наличие
капсулы, споры и отношение возбудителя к
красителям.
Используется для
диагностики:
гонореи,
сифилиса,
дифтерии и др.
Чумная палочка
22.
Микробиологический методСуть метода: выделение и изучение чистой
культуры м/о
Культурой называются м/о, выращенные на
искусственных питательных средах в
лабораторных условиях.
Чистая культура – это культура, состоящая из
одного вида м/о
Используется для
диагностики:
холеры,
дизентерии,
брюшного тифа и др.
23.
Микробиологический метод- это «золотой стандарт» микробиологической
диагностики. Результаты микробиологических
исследований позволяют точно установить факт
наличия возбудителя в исследуемом материале.
Идентификацию чистых культур проводят до вида
микроорганизма.
Чистые
культуры
Кишечная палочка
Золотистый стафилококк
24.
Серологический методСуть метода: выявление в сыворотке крови антител
(защитных белков), вырабатываемых организмом в
ответ на введение генетически чужеродных агентов –
антигенов.
Используют для
диагностики:
гепатита,
полиомиелита,
гриппа и др.
25. 9
Биологическийметод
9
Суть метода: введение подопытным животным чистой
культуры м/о, исследуемого материала с целью
получения характерных для данной инфекции
изменений.
Используют для
диагностики:
столбняка,
ботулизма и др.
26.
Аллергический методСуть метода: позволяет поставить диагноз с
помощью накожных и внутрикожных аллергических
проб. Метод выявляет состояние
гиперчувствительности замедленного типа,
возникающее при ряде инфекционных болезней.
Используют для
диагностики
туберкулёза,
сифилиса,
токсоплазмоза и др.
27.
Молекулярно-генетический методСуть метода: позволяет найти в любом материале даже
фрагменты генетического материала бактериального,
вирусного и др. происхождения, а затем
многократно его размножить (ПЦР – полимеразная цепна
реакция).